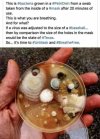
bacteria_in_masks.jpg

You found a crappy study that suggests some effectiveness from wearing a mask. Unfortunately, it's wrong. You have to be careful with the studies you pick and how you are analyzing them. The authors would never dare criticize what's going because they don't want to get blacklisted. That's why even in studies where for example, some new deadly information about the vaccine is mentioned, the authors will always end the study praising the "vaccine". You have to read the studies line by line and then you can see what they are really trying to say.
It's wells established that masks do not stop transmission. Even me, who wears an N95 mask, knows that even that high level of mask, is absolutely not enough. I still wear it because I feel or believe that if it fits me perfectly, it would work, but I admit that the science shows it doesn't work.
I also reuse my mask only a few times at most, and then I throw it away. No one does that. I know it's expensive, but people genuinely don't understand how all of this works and they wouldn't replace their masks even if they could afford to. I also bake my mask in the oven to disinfect. No one does that.
Almost no one wears a mask properly. Poorly fitting, dirty masks, are not going to do anything but harm the person wearing it.